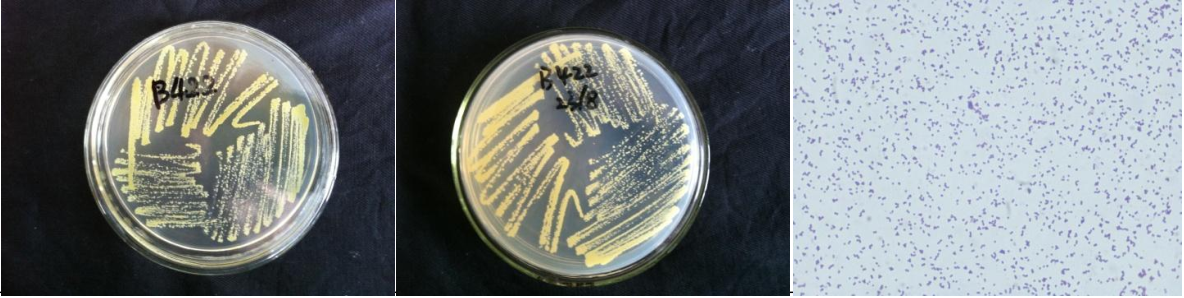

Loading...
| StrainNO | B422 |
| Classification | Staphylococcus |
| 16s rDNA sequence | TATACATGCAAGTCGAGCGAACAGATAAGGAGCTTGCTCCTTTGACGTTAGCGGCGGACGGGTGAGTAACACGTGGGTAACCTAC CTATAAGACTGGGATAACTTCGGGAAACCGGAGCTAATACCGGATAATATTTCGAACCGCATGGTTCGATAGTGAAAGATGGTTT TGCTATCACTTATAGATGGACCCGCGCCGTATTAGCTAGTTGGTAAGGTAACGGCTTACCAAGGCGACGATACGTAGCCGACCTG AGAGGGTGATCGGCCACACTGGAACTGAGACACGGTCCAGACTCCTACGGGAGGCAGCAGTAGGGAATCTTCCGCAATGGGCGAA AGCCTGACGGAGCAACGCCGCGTGAGTGATGAAGGTCTTCGGATCGTAAAACTCTGTTATTAGGGAAGAACATACGTGTAAGTAA CTGTGCACGTCTTGACGGTACCTAATCAGAAAGCCACGGCTAACTACGTGCCAGCAGCCGCGGTAATACGTAGGTGGCAAGCGTT ATCCGGAATTATTGGGCGTAAAGCGCGCGTAGGCGGTTTTTTAAGTCTGATGTGAAAGCCCACGGCTCAACCGTGGAGGGTCATT GGAAACTGGAAAACTTGAGTGCAGAAGAGGAAAGTGGAATTCCATGTGTAGCGGTGAAATGCGCAGAGATATGGAGGAACACCAG TGGCGAAGGCGACTTTCTGGTCTGTAACTGACGCTGATGTGCGAAAGCGTGGGGATCAAACAGGATTAGATACCCTGGTAGTCCA CGCCGTAAACGATGAGTGCTAAGTGTTAGGGGGTTTCCGCCCCTTAGTGCTGCAGCTAACGCATTAAGCACTCCGCCTGGGGAGT ACGACCGCAAGGTTGAAACTCAAAGGAATTGACGGGGACCCGCACAAGCGGTGGAGCATGTGGTTTAATTCGAAGCAACGCGAAG AACCTTACCAAATCTTGACATCCTTTGACAACTCTAGAGATAGAGCTTTCCCCTTCGGGGGACAAAGTGACAGGTGGTGCATGGT TGTCGTCAGCTCGTGTCGTGAGATGTTGGGTTAAGTCCCGCAACGAGCGCAACCCTTAAGCTTAGTTGCCATCATTAAGTTGGGC ACTCTAAGTTGACTGCCGGTGACAAACCGGAGGAAGGTGGGGATGACGTCAAATCATCATGCCCCTTATGATTTGGGCTACACAC GTGCTACAATGGACAATACAAAGGGCAGCGAAACCGCGAGGTCAAGCAAATCCCATAAAGTTGTTCTCAGTTCGGATTGTAGTCT GCAACTCGACTACATGAAGCTGGAATCGCTAGTAATCGTAGATCAGCATGCTACGGTGAATACGTTCCCGGGTCTTGTACACACC GCCCGTCACACCACGAGAGTTTGTAACACCCGAAGCCGGTGGAGTAACCATTTGGAGCTAGCCGT |
| Strain Morphology Photos | |
| Morphological Description | round;ivory yellow;edge neatly;steamed bun shaped;small;slippy;sticky;spherical;no spore |